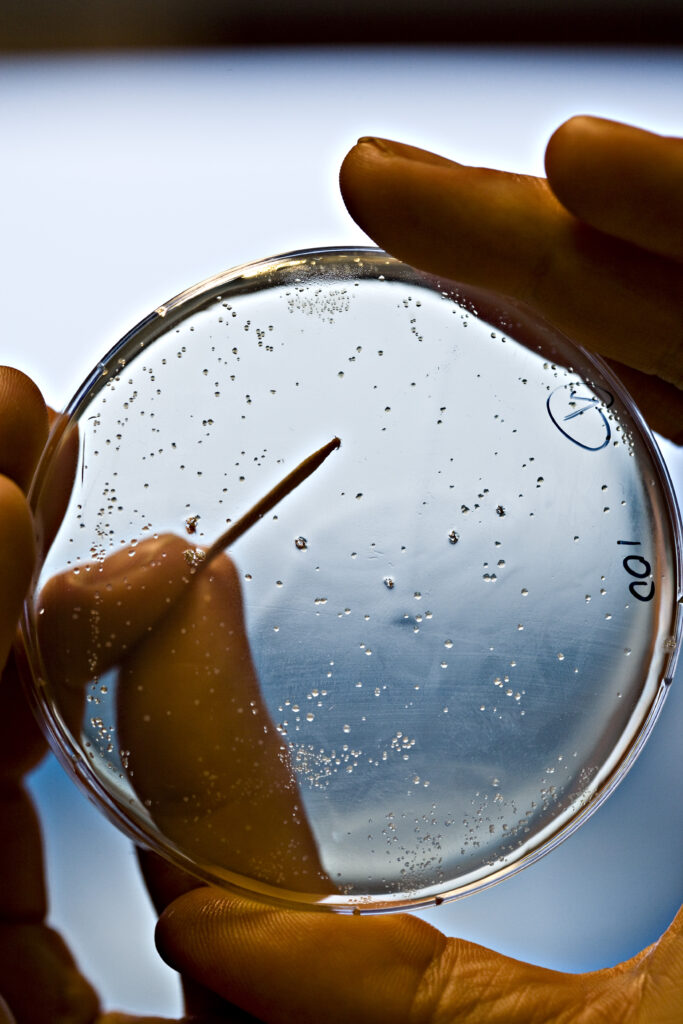

Welkom op onze vernieuwde website!
Graag informeren we je dat onze website een vernieuwde lay-out en structuur heeft gekregen. Met deze aanpassing presenteren we onze informatie op een overzichtelijkere en eigentijdse wijze. Het vernieuwde ontwerp zorgt ervoor dat je als bezoeker gemakkelijker kunt navigeren en sneller vindt wat je zoekt. We nodigen je van harte uit om een kijkje te nemen op onze vernieuwde website!